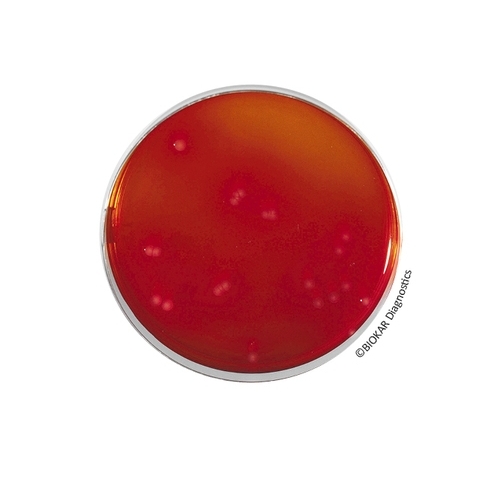
Brıllıant Green Agar (EDEL & KAMPELMACHER)

Brilliant Green Agar (EDEL & KAMPELMACHER)
Brilliant Green agar according to Edel & Kampelmacher is a selective medium used to isolate Salmonella in milk and dairy products. This media can also be used as a second isolation media in the context of the various normalized methods for the detection of Salmonella spp.
| Ürün Adı | Brıllıant Green Agar (EDEL & KAMPELMACHER) |
| Ürün Kodu | BK091HA |
| Miktar | 500 g |